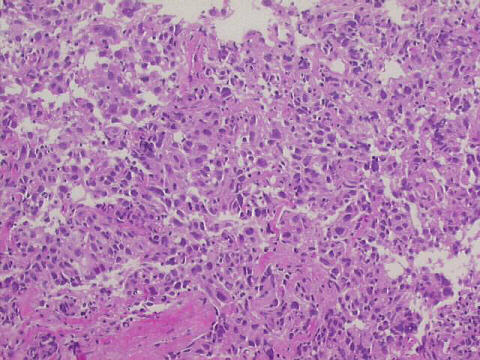
100x HE staining, core biopsy
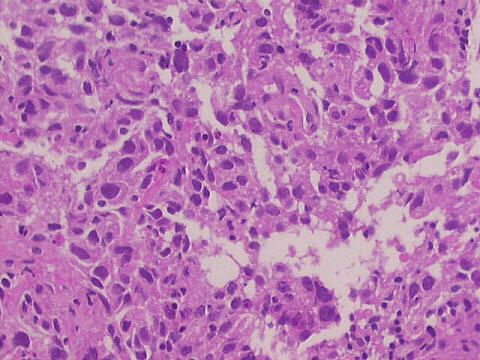
200x HE staining, core biopsy

|




>
center>
FNA cytology: many disperse "dyscohesive" malignant cells were seen, specially in the M-G-G stained smears, a quite specific pattern for malignancy. Its prognostic significance is controverse. Core biopsy revealed invasive ductal carcinoma. At surgery, confirmation of the diagnosis, and several axillary lymph nodes positive for metastases.

|

